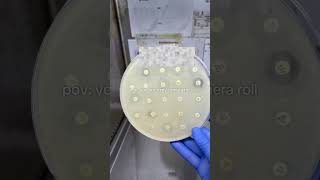

Shared 6 months ago
3.8K views
Shared 2 years ago
190 views
Shared 2 years ago
22K views
Shared 1 month ago
97 views
Shared 2 years ago
268K views
You call it love life we call it lab life We are not the same vro🧪🔬🧫🧬 vro#instareels#lablove#unilife
Shared 9 months ago
563 views
Shared 7 months ago
501 views
Shared 5 months ago
388 views
Shared 5 months ago
492 views
Shared 9 months ago
3.6K views
Shared 2 years ago
927 views
Shared 7 months ago
166 views
Shared 1 year ago
1K views
Shared 5 months ago
485 views
Shared 3 months ago
2.3K views
Shared 4 months ago
88 views
Shared 7 months ago
444 views
Shared 5 months ago
72 views
Shared 1 year ago
126 views
Shared 8 months ago
969 views
Shared 4 months ago
642 views
Shared 5 months ago
1.9K views
Shared 4 months ago
109 views
Shared 6 months ago
15 views
Shared 7 months ago
2.6K views
Shared 10 months ago
1.4K views
Shared 8 months ago
808 views
Shared 5 months ago
1.8K views